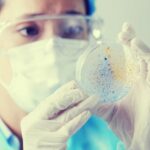
lkdjjdslkfjs

La gobernadora de Aguascalientes, Tere Jiménez, sostuvo una reunión de trabajo con altos directivos de la empresa Mercedes Benz U.S. International Inc., ante quienes refrendó el respaldo de su administración para que las operaciones de esta empresa automotriz sigan desarrollándose con éxito en la Entidad.
“Saben que cuentan con nosotros. Tenemos todo el potencial para que sigan creciendo; siempre van a tener nuestro respaldo para que les vaya bien, porque si a ustedes les va bien, a México y a Aguascalientes les irá mejor”, le dijo la gobernadora al grupo encabezado por Michael Goebel, Head of Operations North America de Mercedes Benz U.S. International Inc.
Durante el encuentro, Tere Jiménez expuso las principales ventajas competitivas que ofrece Aguascalientes a los inversionistas, así como algunos de los proyectos que se prevé desarrollar en el corto plazo para fortalecer algunos rubros que inciden en la atracción de nuevos capitales a esta Entidad, como seguridad, abastecimiento de agua, suficiencia energética, infraestructura carretera y ferroviaria, entre otros.
Asimismo, hizo hincapié en que el clima de colaboración Estado-Federación es muy positivo y se vislumbran políticas conjuntas que favorecerán el desarrollo económico y la inversión extranjera.
Por su parte, Michael Goebel agradeció el apoyo y la excelente colaboración que existe entre Mercedes Benz y el Gobierno del Estado, lo cual ha sido determinante durante los 10 años que tienen presencia en Aguascalientes; asimismo reconoció el buen clima laboral y los niveles de seguridad que prevalecen en la Entidad.
En el encuentro que se realizó en Palacio de Gobierno, por parte de Mercedes Benz U.S. International Inc., también estuvieron presentes Alexander Hirt, Manager North America Operations Strategy; Lauren Brown, Supply Chain Manager; Francisco Javier González Zamudio, General Counsel; Andrea Palomera Vieyra, Associate General Counsel & External Affairs; y Alexander Kurz, CEO; además de Esaú Garza de Vega, titular de la Secretaría de Desarrollo Económico, Ciencia y Tecnología (Sedecyt); Jorge Andrade Serafín, subsecretario de Inversión y Desarrollo de la Sedecyt; y Giovani González Severo, director general de Desarrollo Industrial de la Sedecyt.